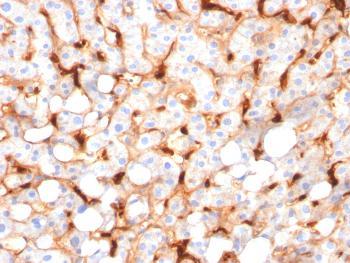

Anti-C1QB / Complement C1q B-Chain Monoclonal Antibody(Clone: C1QB/2966)
Fig. 1: Formalin-fixed, paraffin-embedded human Hepatocellular Carcinoma stained with C1QB Mouse Monoclonal Antibody (C1QB/2966).
Roll over image to zoom in
Shipping Info:
For estimated delivery dates, please contact us at [email protected]
Amount : | 100 µg |
Isotype : | Mouse IgG1, kappa |
Content : | 200 µg/ml of Ab Purified from Bioreactor Concentrate by Protein A/G. Prepared in 10mM PBS with 0.05% BSA & 0.05% azide. Also available WITHOUT BSA & azide at 1.0mg/ml. |
Storage condition : | Antibody with azide - store at 2 to 8°C. Antibody without azide - store at -20 to -80°C. Antibody is stable for 24 months. Non-hazardous. |
Immunohistochemistry (Formalin-fixed) (1-2ug/ml for 30 minutes at RT)(Staining of formalin-fixed tissues requires heating tissue sections in 10mM Tris with 1mM EDTA, pH 9.0, for 45 min at 95°C followed by cooling at RT for 20 minutes)
For Research Use Only. Not for use in diagnostic/therapeutics procedures.
There are currently no product reviews
|